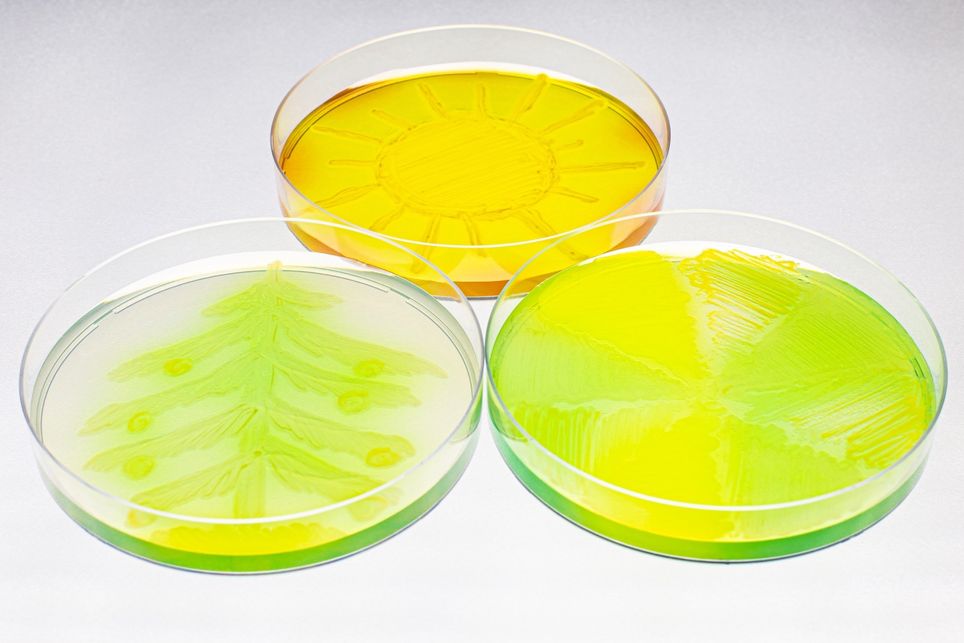
bactéria, colonias bactéria, colonias

Pesquisadores da USP mostraram que inocular sementes de capim com bactérias aliadas mantém fotossíntese, produtividade e qualidade do forragem mesmo com +2 °C, oferecendo alternativa barata, segura, sustentável para adaptar e mitigar impactos climáticos na pecuária tropical.
A elevação constante das temperaturas ameaça não apenas o conforto humano, mas também a produtividade das pastagens que sustentam a pecuária brasileira. Pesquisadores da Universidade de São Paulo (USP) decidiram encarar o desafio de frente e testaram uma solução inusitada: inocular sementes de capim tropical com bactérias benéficas que atuam como promotoras de crescimento.
O resultado foi surpreendente. Mesmo sob calor extra, as plantas tratadas mantiveram a fotossíntese, cresceram mais e ainda melhoraram a qualidade nutricional do forragem. A descoberta sugere que pequenas aliadas invisíveis, Azospirillum brasilense e Pseudomonas fluorescens, podem funcionar como um “ar‑condicionado biológico”, permitindo que a pecuária tropical produza leite e carne sem sacrificar carbono e nutrientes.
Como as bactérias ajudam as plantas a enfrentar o calor
Sob temperaturas elevadas, as folhas fecham seus estômatos, a fotossíntese cai e a planta entra em modo de sobrevivência. As bactérias PGPB (Plant Growth‑Promoting Bacteria) mudam esse roteiro de três maneiras principais:
- Raízes mais profundas: elas estimulam o crescimento radicular, permitindo que a planta acesse água em camadas mais fundas do solo.
- Sistema antioxidante turbinado: enzimas protetoras neutralizam radicais livres gerados pelo excesso de calor e luz.
- Economia de energia: ao fixar nitrogênio atmosférico, as PGPB reduzem a dependência de fertilizantes, poupando a planta de gastos metabólicos extras.
Graças a esse trio de benefícios, o capim inoculado manteve o teor relativo de água nas folhas e, com isso, continuou capturando carbono mesmo quando o termômetro subiu.
Do laboratório ao campo: o teste em +2 °C
Para verificar se a teoria se sustenta fora das estufas, o grupo da USP montou um sistema T‑FACE (Temperature Free‑Air Controlled Enhancement) que aquece a pastagem em campo aberto usando aquecedores infravermelhos. Durante um ano, quatro ciclos de corte foram acompanhados: metade sob temperatura ambiente e metade com acréscimo de 2 °C; em cada ambiente, parcelas sem e com inoculação.

Os resultados foram claros. Sem inoculação, o aquecimento reduziu a produção de biomassa e a digestibilidade do capim em até 15 %. Já nas parcelas inoculadas, não houve perda, em alguns parâmetros, como teor de proteína bruta, houve até ganho. A fluorescência da clorofila mostrou que o fotossistema II, termômetro da saúde fotossintética, permaneceu intacto quando as bactérias estavam presentes.
Impacto na pecuária e no clima
Mais produtivo e nutritivo, o capim inoculado significa rebanhos que comem menos para ganhar o mesmo peso, um ponto crucial em tempos de pressão por reduzir emissões de metano. Além disso, a menor necessidade de adubar reduz a liberação de óxido nitroso, gás até 300 vezes mais potente que o CO₂.
De quebra, pequenos produtores se beneficiam porque o insumo é barato, pode ser aplicado na própria fazenda e não demanda tecnologias sofisticadas. O estudo da USP expõe um paradoxo esperançoso: enquanto o aquecimento global pressiona nossos sistemas agrícolas, a resposta pode vir de organismos microscópicos que evoluíram junto às plantas há milhões de anos.
Para que o potencial vire realidade, faltam ensaios em outras regiões, avaliação de custos a longo prazo e políticas que facilitem o uso desses bioinsumos. Mas uma lição já está clara: às vezes, a solução mais poderosa cabe em uma gota, a que cobre a semente antes de ela tocar o solo quente.
Referência da notícia
Inoculation with plant growth-promoting bacteria mitigates the negative impacts of 2 °C warming on the photosynthesis, growth, and nutritional value of a tropical C4grassland under field conditions. 1 de março, 2025. Habermann, E. et., al.
